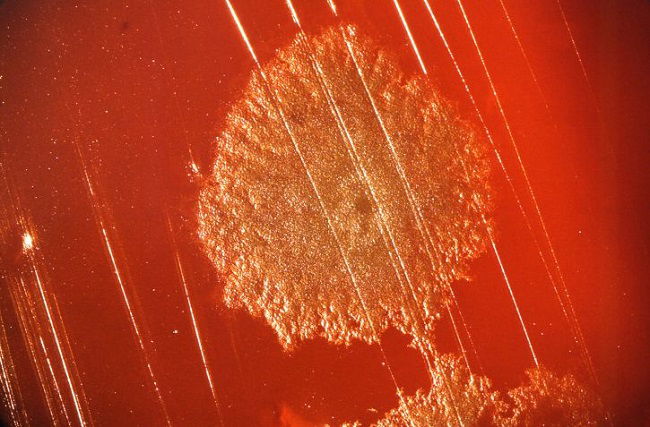
Clostridium botulinum, la bacteria causante del botulismo

Reino Monera
El reino Monera es el nombre de una clasificación de los seres vivos que agrupaba a los organismos unicelulares procariotas y estaba compuesto principalmente por bacterias y arqueas, las formas de vida más abundantes del planeta.
Los organismos procariotas están compuestos por una sola célula sin núcleo definido. De hecho, la palabra monera viene del griego moneres, que hace referencia a lo “simple” y “solitario”. De ahí que usara para describir a los organismos de este reino.
Actualmente, el reino Monera no es considerado uno de los siete reinos de la naturaleza. Estos organismos ahora se clasifican en dos reinos diferentes:
- arqueas (reino Archaea)
- y bacterias (reino Bacteria).
Pero, ¿por qué el Monera fue considerado un reino aparte durante tanto tiempo? En 1866, el naturalista alemán Ernst Haeckel había dividido en tres grandes grupos a los seres vivos: Animalia, Plantae y Protista.
Los organismos del reino Monera formaban parte del reino Protista en una de sus subdivisiones, en las cuales también se englobaban a los organismos de células eucariotas.
Pero más tarde, en el año 1920, el biólogo francés Édouard Chatton descubrió la existencia de las células sin núcleo definido y estableció dos grupos de células que nombró como eucariotas y procariotas.
Posteriormente, Hebert Copeland, un biólogo estadounidense, propuso en el año 1938 la creación del reino Monera, en el cual estaban los organismos procariotas.
Sin embargo, en la década de los años 1970, el microbiólogo estadounidense Carl Woese notó que dentro del reino Monera existían dos grupos diferentes: las bacterias y las arqueas, dando pie a la creación de dos nuevos reinos, con lo cual el Monera dejó de ser considerado un reino en sí mismo.
Ver también: Los 5 Reinos de la Naturaleza y Protozoarios
Características del reino Monera

Entre las características generales que diferencian a los organismos que pertenecen al reino Monera se pueden nombrar las siguientes:
- Son procariotas: es decir, carecen de núcleo celular.
- Son los organismos celulares más pequeños que se han encontrado, entre 0,2 y 3 micras de diámetro.
- Su respiración puede ser aeróbica o anaeróbica, es decir, que algunas de las bacterias de este reino necesitan oxígeno para existir y otras no.
- Pueden vivir de manera individual o grupal, como las bacterias que forman colonias.
- Pueden moverse de forma autónoma, gracias a los cilios y flagelos que poseen algunos de estos organismos.
- Su hábitat es variado, pueden encontrarse tanto en la tierra como en el agua, sobre otros seres vivos y dentro de estos.
- Se reproducen de manera asexual, por escisión o bipartición.
- La nutrición suele ser heterótrofa, dependen de otros organismos para obtener su sustento. En algunos casos es autótrofa cuando pueden sintetizar sus propios nutrientes.
- La morfología es variada, algunos tienen forma redonda, de bastón o sacacorchos.
Clasificación del reino Monera
La clasificación de las bacterias se modificó a lo largo de los años gracias a los nuevos hallazgos realizados por los científicos. En principio había dos clasificaciones, las bacterias y las cianobacterias.
Luego se empleó la clasificación propuesta por Woese que estaba conformada por cuatro divisiones:
Arqueobacterias
Son microorganismos procariotas unicelulares. Su nombre se debió a su similitud con las bacterias, aunque hoy en día se sabe que se trata de organismos diferentes e incluso, tienen su propio reino (Archaea).
Algunos ejemplos de arqueobacterias son la arquea metanógena, la crenarchaeota, y la halobacteria.
Gram positivas
Son microorganismos procariotas con una pared celular rica en peptodoglicano, una malla de aminoácidos y azúcares que protege la membrana celular de la bacteria.
Ejemplos de este tipo de microorganismos son los lactobacilos, los micrococos, los estafilococos y las actinobacterias.
Gram negativas
Son bacterias cuya pared celular es pobre en peptidoglicano pero rica en lípidos.
Los meningococos, las clamidias y las bacterias intestinales, como la Escherichia coli, son algunos ejemplos.
Micoplasmas
Son bacterias que no tienen pared celular, muy difíciles de detectar en el microscopio debido a su tamaño casi imperceptible. Algunas de ellas son parásitos patógenos de vertebrados, incluyendo a los seres humanos.
Ejemplos de micoplasmas son las bacterias anaeroplasmatales, entomoplasmatales, mycoplasmatales y el Mycoplasma pneumoniae, que puede causar neumonía en los seres humanos.
Ejemplos del reino Monera
A continuación, se presentan algunos ejemplos de los organismos que se consideraban como parte del reino Monera, que son en gran medida bacterias.
- Chlamydia trachomatis: bacteria Gram negativa causante de infecciones de transmisión sexual.
- Vibrio vulnificus: es una bacteria Gram negativa que provoca infecciones en el ser humano.
- Bifidobacterias: bacterias que se encuentran en el colon y participan en la digestión.
- Escherichia coli: bacteria que causa infecciones gastrointestinales.
- Lactobacillus casei: es una bacteria Gram positiva, produce ácido láctico y se encuentra en los intestinos y boca de los seres humanos.
- Clostridium botulinum: es un bacilo que se encuentra en la tierra y que genera la toxina causante del botulismo.
Vea también:
- Los 7 Reinos de la naturaleza (lista actualizada)
- Reino animal
- Reino Plantae
- Reino Fungi
- Reino Protista
- Clasificación de los seres vivos en dominios y reinos
Cómo citar: Significados, Equipo (05/09/2022). "Reino Monera". En: Significados.com. Disponible en: https://www.significados.com/reino-monera/ Consultado: